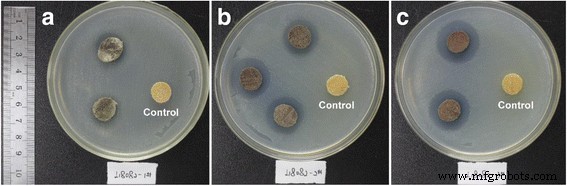
Pure Copper Nanoparticles via Wood Template: Synthesis, Characterization, and Antibacterial Performance

Pure Copper Nanoparticles via Wood Template: Synthesis, Characterization, and Antibacterial Performance
Abstract
Poplar wood’s intricate cellular architecture offers a cost‑effective, renewable scaffold for nanoparticle synthesis. In this study, we successfully reduced copper(II) chloride within poplar wood, producing copper nanoparticles that are uniformly sized, face‑centered cubic, and highly stable. X‑ray diffraction and field‑emission scanning electron microscopy confirm the crystalline structure and corncob‑like assembly along cell lumina. Optical absorption peaks near 565 nm and pronounced antibacterial activity against Escherichia coli were observed, highlighting the hybrid material’s multifunctionality.
Background
Metal nanoparticles have captured significant scientific interest because of their remarkable physicochemical traits. Silver and gold, prized for their plasmonic resonance and stability, remain costly, limiting large‑scale use. Copper, being abundant and inexpensive, emerges as a viable alternative, offering catalytic, optical, antibacterial, and electrical conducting properties. Realising these benefits demands precise control over copper’s size, purity, and shape. Various synthesis routes—solution‑phase reduction, thermal decomposition, vapor synthesis, radiation methods, microemulsion, mechanical attrition, and electrodeposition—have been examined. Among them, solution reduction stands out for its versatility; however, it often yields spherical particles. Achieving distinct morphologies typically requires elaborate organic or inorganic templates, which can be costly and labor‑intensive.
Oxidation of copper nanoparticles in ambient air leads to surface CuO formation and aggregation, compromising performance. Conventional strategies mitigate this by conducting synthesis under inert atmospheres or applying protective layers (polymers, ligands, carbon, graphene, or inert metals). These approaches, though effective, add complexity and equipment demands.
Wood’s natural hierarchical and anisotropic structure presents an attractive, inexpensive template. Its porous network—from nanometer to micrometer scales—allows deep penetration of reagents. Previous work has used wood to scaffold responsive gels and to assemble ZnO nanostructures, yielding materials with superior thermal stability, UV resistance, and antibacterial activity. Wood’s lignocellulosic components—cellulose, lignin, and hemicellulose—contain abundant hydroxyl and phenolic groups that can reduce and stabilize metal ions, as demonstrated by Lin et al. for Pt and Ag nanoparticles. Nevertheless, copper nanoparticles synthesized within wood have often suffered oxidation, underscoring the need for a more robust approach.
Here, we report a novel method for synthesizing pure copper nanoparticles inside poplar wood by chemical reduction. The resulting hybrid material exhibits a unique corncob‑like assembly along cell lumina, high stability, strong optical absorption, and effective antibacterial activity.
Methods/Experimental
Materials
Fresh sapwood from Populus tomentosa (poplar) was cut into blocks of 50 × 50 × 5 mm³ (longitudinal) and oven‑dried at 103 °C until constant weight. Copper(II) chloride dihydrate (CuCl₂·2H₂O) and sodium borohydride (NaBH₄) were purchased from Sinopharm Chemical Reagent Co., Ltd. (Shanghai, China). Other analytical‑grade reagents were sourced from Beijing Chemical Reagents Co., Ltd. (Beijing, China).
Preparation of Wood/Cu Composites
The fabrication workflow is illustrated in Fig. 2. CuCl₂·2H₂O was dissolved in water and the pH was adjusted with stoichiometric NaOH. Wood samples were first immersed in the copper solution under vacuum (~0.095 MPa) for 30 min to promote ion infiltration, followed by atmospheric soaking for 2 h. After rinsing, the samples were immediately submerged in 200 mL NaBH₄ solution containing varying NaOH concentrations for 48 h. Finally, the composites were washed with deionised water until neutral pH, then oven‑dried at 30 °C for 72 h. Detailed solution formulations are provided in Table 1.

Fabrication process of hybrid wood materials
Characterization of Cu Nanostructures
X‑ray diffraction (XRD) was performed on a Bruker D8 Advance diffractometer (Cu‑Kα, λ = 0.15418 nm, 40 kV, 40 mA, 2θ = 5–90°, 2°/min). Field‑emission scanning electron microscopy (FE‑SEM, Hitachi SU8010) equipped with an energy‑dispersive X‑ray spectrometer (EDS, EX‑350) was used to examine morphology. Samples were cut longitudinally, mounted on conductive tape, gold‑sputtered, and imaged at 5 kV.
Evaluation of Optical and Antibacterial Properties
Diffuse‑reflectance UV‑VIS spectra (Cary‑300) were recorded from 800 to 300 nm using an integrating sphere. For antibacterial testing, the composites were machined into 10 mm diameter discs. A bacterial suspension of E. coli was spread on nutrient agar plates, and discs were placed on the surface (one control and two treated per plate). After 24 h incubation at 37 °C, inhibition zones were measured to the nearest 0.1 mm.
Results and Discussion
X‑ray Diffraction Analysis
Figure 3a shows XRD patterns for groups A–D. Peaks at 15.9°, 22.1°, and 34.5° correspond to cellulose (101, 002, 040). The sharp reflections at 43.3°, 50.4°, and 74.1° arise from Cu (111, 200, 220) and confirm an fcc structure (JCPDS No. 85–1326). Minor peaks near 29.7°, 36.4°, 42.2°, and 61.4° in groups A and B are attributable to Cu₂O (110, 111, 200, 220). Thus, the Cu‑product composition is strongly governed by the initial OH⁻ concentration: at low OH⁻, both Cu and Cu₂O appear; at ≥1.0 mol L⁻¹, only metallic Cu remains. The pH adjustment to 10–12 via NaOH not only drives Cu(OH)₂ formation but also accelerates the reduction by NaBH₄ (which loses reducing power below pH 9.5). Wood’s hierarchical structure limits particle growth, keeping the grain size constant even as Cu²⁺ concentration increases.

XRD patterns of groups A–D (a) and groups C, E, F (b)
Increasing Cu²⁺ concentration (groups C, E, F) intensified Cu diffraction peaks, confirming higher nanoparticle load. The Scherrer equation was employed to estimate crystallite size. Using (110), (200), and (220) peaks, the average diameters were 19.5 nm (C), 19.7 nm (E), and 21.3 nm (F) (Table 2), indicating that wood’s confined geometry restrains growth regardless of Cu²⁺ load.
After one year of ambient storage, XRD patterns (Fig. 4) revealed only a minor CuO peak at 38.9°. Grain sizes remained unchanged, underscoring the hybrid’s resistance to oxidation and aggregation—a direct benefit of wood’s protective matrix and inherent components.

XRD patterns of groups C, E, F after one year of storage
Morphology Analysis
FE‑SEM images (Fig. 5) reveal a distinctive corncob‑like assembly of Cu nanostructures along the wood cell lumina. The smooth lumen walls (Fig. 1b) contrast with the densely packed nanoparticles, as confirmed by EDS mapping (Fig. 6). The anisotropic wood scaffold directs the growth, imparting directional order.

FE‑SEM of Cu NPs in poplar wood (group F). a Lumina‑aligned nanostructures. b, c Magnified views

SEM/EDS of Cu distribution. Top: secondary structures on lumen wall; bottom: main structures on lumen wall
In the wood pits, Cu nanoparticles formed smaller, spherical agglomerates (1–2.5 µm) (Fig. 7). These confined morphologies result from pit geometry, demonstrating that wood’s architecture can dictate nanoparticle shape beyond traditional precipitation methods. This controlled assembly could enable tailored optical and electrical properties in wood‑based composites.

Cu NPs in wood pits (group F). a 2 k×, b 10 k×
Optical and Antibacterial Properties
Diffuse‑reflectance UV‑VIS spectra (Fig. 8) show a pronounced plasmon peak at 565 nm for the hybrid materials, aligning with the known Cu NP absorption band (560–570 nm). The intensity increases with Cu content, confirming the successful incorporation of metallic copper.

UV‑Vis spectra of original and hybrid wood
Antibacterial assays (Fig. 9) reveal clear inhibition zones for all treated samples versus control. The average diameters of inhibition zones were 0 mm (control), 3.2 mm (group C), 4.8 mm (group E), and 6.2 mm (group F), demonstrating a Cu‑concentration‑dependent antibacterial effect. These results affirm that embedding copper nanoparticles into wood imparts potent antimicrobial activity without compromising the wood’s structural integrity.
Antibacterial testing of original and hybrid wood. a Group C. b Group E. c Group F
Conclusions
Leveraging poplar wood’s hierarchical, anisotropic architecture and electron‑rich lignocellulosic components, we produced pure copper nanoparticles with a distinctive corncob‑like arrangement along cell lumina. The Cu₂O fraction diminishes as the initial OH⁻ concentration rises, yielding nearly phase‑pure metallic copper. Incremental Cu²⁺ loading increases nanoparticle density without altering grain size, thanks to wood’s confined geometry. The wood matrix protects the copper from oxidation and aggregation, ensuring stability over a year of ambient storage. Combined with copper’s inherent optical and antibacterial properties, this hybrid material offers a lightweight, cost‑effective platform for advanced wood‑based applications.
Nanomaterials
- Magnetite Nano‑Adsorbent from Mill Scale Waste Efficiently Removes Cu(II) from Water: Synthesis, Characterization, Adsorption Kinetics and Regeneration
- Eco‑Friendly Copper Oxide Nanoparticles Doped with Ginger and Garlic Extracts Exhibit Potent Antibacterial Activity Against Escherichia coli
- Green Production of Copper Nanoparticles: Catalytic, Antibacterial, Cytotoxic, and Antioxidant Potentials
- Optimized Fe³⁺‑Grafted BiOCl for Rapid Adsorption of Trace Cationic and Anionic Dyes in Aqueous Wastewater
- One‑Step Acoustic Levitation Enables Rapid Synthesis of Single‑Atom Platinum Nanoclusters and Pt‑Decorated Microporous La₂O₃ for Catalysis
- Rapid One‑Pot Synthesis of Monodisperse CoFe₂O₄@Ag Core–Shell Nanoparticles with Exceptional Plasmonic and Magnetic Properties
- Hierarchical ZSM‑5 Zeolites with Exceptional Mesoporosity and Catalytic Performance: A Novel Soft‑Template Approach
- Hierarchical Au@CdS‑CdS Nanoflowers: Stepwise Fabrication and Superior Photocatalytic Performance
- Green Synthesis of Gold Nanoparticles with Mimosa tenuiflora Bark Extract: Cytotoxicity, Cellular Uptake and Catalytic Degradation of Methylene Blue
- Controlled Growth of Vertically Aligned ZnO Nanorods via Sol‑Gel Seeding and Colloidal Lithography on Si(100) Substrates